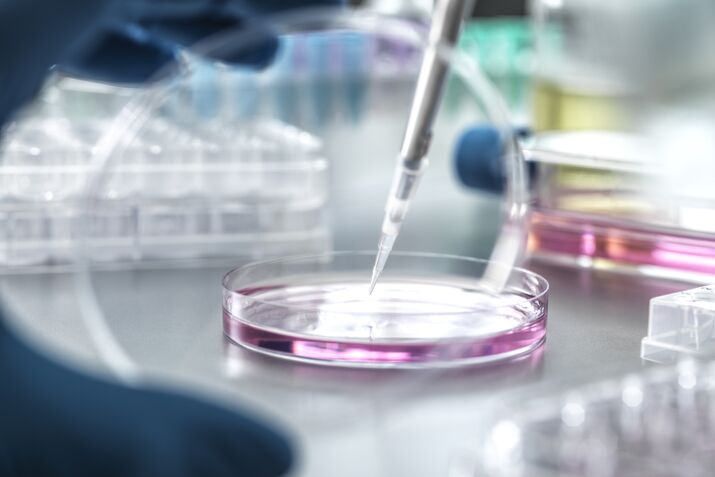
Scientist pipetting medical samples into petri dish in laboratory

Watch: Fatal Shooting at Sydney’s Bondi on Hanukkah

Subscriber Only
Get The Forecast newsletter.

Subscriber Only
Get the Markets Daily newsletter.
Your News.

Bloomberg Businessweek
How Billionaire Wes Edens’ Big Energy Dream Hit the Rocks
The Cracks in Crumbl’s Cookie Empire Are Showing

No comments:
Post a Comment